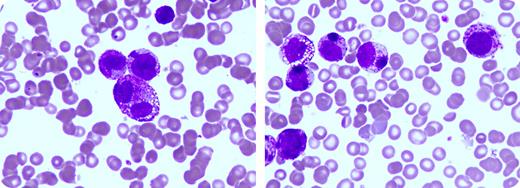
A 61-year-old male was evaluated for 3 months of abdominal pain, weight loss, and low-grade fever. He had pallor and hepatosplenomegaly. A complete blood count showed hemoglobin of 9.8 g/dL, white blood cell count of 6.9 × 109/L, and platelet count of 4.0 × 109/L. The peripheral blood smear revealed anisocytosis, polychromasia, nucleated red blood cells, early myeloid cells, and marked thrombocytopenia. Bone marrow aspirate showed diffuse infiltration with pleomorphic mononuclear cells forming clusters. These cells were large, some binucleated (left panel) with prominent granulation, noticeable vacuolization, and a rare, large, basophilic inclusion (right panel). These cells were negative with Sudan black B and periodic acid Schiff. Immunotyping was positive for leukocyte common antigen and CD30 and negative for CD3, CD20, Tdt, CD34, CD68, CKAE1/AE3, CD117, and PAX5. The anaplastic lymphoma kinase (ALK) protein was negative. / A diagnosis of anaplastic large cell lymphoma (ALCL), ALK negative was made. ALCL is an infrequent, aggressive T-cell lymphoma. Until recently it was considered a single disease with few distinctions between cases that were ALK positive and negative. Currently, ALK negative disease is recognized as a separate entity associated with morphologic differences, decreased response rates to therapy, and a poorer prognosis compared with ALCL, ALK positive tumors.

A 61-year-old male was evaluated for 3 months of abdominal pain, weight loss, and low-grade fever. He had pallor and hepatosplenomegaly. A complete blood count showed hemoglobin of 9.8 g/dL, white blood cell count of 6.9 × 109/L, and platelet count of 4.0 × 109/L. The peripheral blood smear revealed anisocytosis, polychromasia, nucleated red blood cells, early myeloid cells, and marked thrombocytopenia. Bone marrow aspirate showed diffuse infiltration with pleomorphic mononuclear cells forming clusters. These cells were large, some binucleated (left panel) with prominent granulation, noticeable vacuolization, and a rare, large, basophilic inclusion (right panel). These cells were negative with Sudan black B and periodic acid Schiff. Immunotyping was positive for leukocyte common antigen and CD30 and negative for CD3, CD20, Tdt, CD34, CD68, CKAE1/AE3, CD117, and PAX5. The anaplastic lymphoma kinase (ALK) protein was negative.
A diagnosis of anaplastic large cell lymphoma (ALCL), ALK negative was made. ALCL is an infrequent, aggressive T-cell lymphoma. Until recently it was considered a single disease with few distinctions between cases that were ALK positive and negative. Currently, ALK negative disease is recognized as a separate entity associated with morphologic differences, decreased response rates to therapy, and a poorer prognosis compared with ALCL, ALK positive tumors.
A 61-year-old male was evaluated for 3 months of abdominal pain, weight loss, and low-grade fever. He had pallor and hepatosplenomegaly. A complete blood count showed hemoglobin of 9.8 g/dL, white blood cell count of 6.9 × 109/L, and platelet count of 4.0 × 109/L. The peripheral blood smear revealed anisocytosis, polychromasia, nucleated red blood cells, early myeloid cells, and marked thrombocytopenia. Bone marrow aspirate showed diffuse infiltration with pleomorphic mononuclear cells forming clusters. These cells were large, some binucleated (left panel) with prominent granulation, noticeable vacuolization, and a rare, large, basophilic inclusion (right panel). These cells were negative with Sudan black B and periodic acid Schiff. Immunotyping was positive for leukocyte common antigen and CD30 and negative for CD3, CD20, Tdt, CD34, CD68, CKAE1/AE3, CD117, and PAX5. The anaplastic lymphoma kinase (ALK) protein was negative.
A diagnosis of anaplastic large cell lymphoma (ALCL), ALK negative was made. ALCL is an infrequent, aggressive T-cell lymphoma. Until recently it was considered a single disease with few distinctions between cases that were ALK positive and negative. Currently, ALK negative disease is recognized as a separate entity associated with morphologic differences, decreased response rates to therapy, and a poorer prognosis compared with ALCL, ALK positive tumors.
For additional images, visit the ASH IMAGE BANK, a reference and teaching tool that is continually updated with new atlas and case study images. For more information visit http://imagebank.hematology.org.
This feature is available to Subscribers Only
Sign In or Create an Account Close Modal